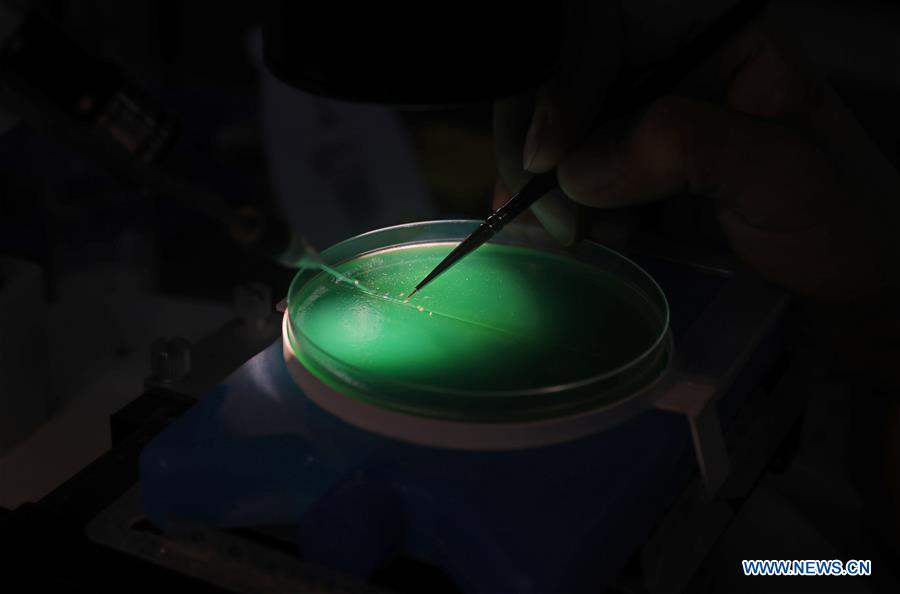

A graduate student does entomological research at a lab of Shenyang Agricultural University during summer vacation in Shenyang, northeast China's Liaoning Province, Aug. 3, 2020. (Xinhua/Yang Qing)

A graduate student does entomological research at a lab of Shenyang Agricultural University during summer vacation in Shenyang, northeast China's Liaoning Province, Aug. 3, 2020. (Xinhua/Yang Qing)